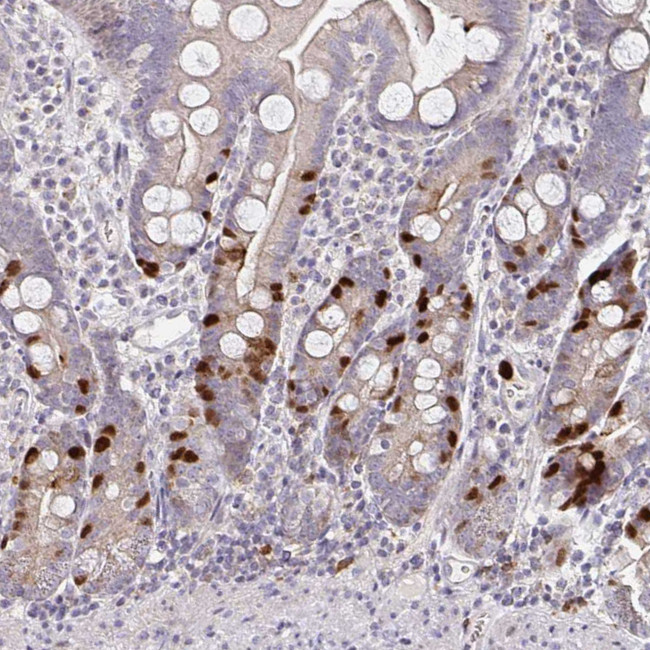
Anillin Antibody in Immunohistochemistry (Paraffin) (IHC (P))

Search
Invitrogen
Anillin Polyclonal Antibody
{{$productOrderCtrl.translations['antibody.pdp.commerceCard.promotion.promotions']}}
{{$productOrderCtrl.translations['antibody.pdp.commerceCard.promotion.viewpromo']}}
{{$productOrderCtrl.translations['antibody.pdp.commerceCard.promotion.promocode']}}: {{promo.promoCode}} {{promo.promoTitle}} {{promo.promoDescription}}. {{$productOrderCtrl.translations['antibody.pdp.commerceCard.promotion.learnmore']}}
产品信息
PA5-82206
种属反应
宿主/亚型
分类
类型
抗原
偶联物
形式
浓度
规格
纯化类型
保存液
内含物
保存条件
运输条件
RRID
产品详细信息
Immunogen sequence: IVKSTLSQTV PSKGELSREI CLQSQSKDKS TTPGGTGIKP FLERFGERCQ EHSKESPARS TPHRTPIITP NTKAIQERLF KQDTSSSTTH LAQQLKQERQ KELACLRGRF DKGNIWSAEK GGNSKSKQLE TKQETH
Highest antigen sequence indentity to the following orthologs: Rat - 76%, Mouse - 76%.
靶标信息
This gene encodes an actin-binding protein that plays a role in cell growth and migration, and in cytokinesis. The encoded protein is thought to regulate actin cytoskeletal dynamics in podocytes, components of the glomerulus. Mutations in this gene are associated with focal segmental glomerulosclerosis 8. Alternative splicing results in multiple transcript variants encoding different isoforms.
仅用于科研。不用于诊断过程。未经明确授权不得转售。
篇参考文献 (0)
生物信息学
蛋白别名: Anillin; DKFZp779A055; unnamed protein product
基因别名: ANLN; FSGS8; scra; Scraps
UniProt ID: (Human) Q9NQW6
Entrez Gene ID: (Human) 54443